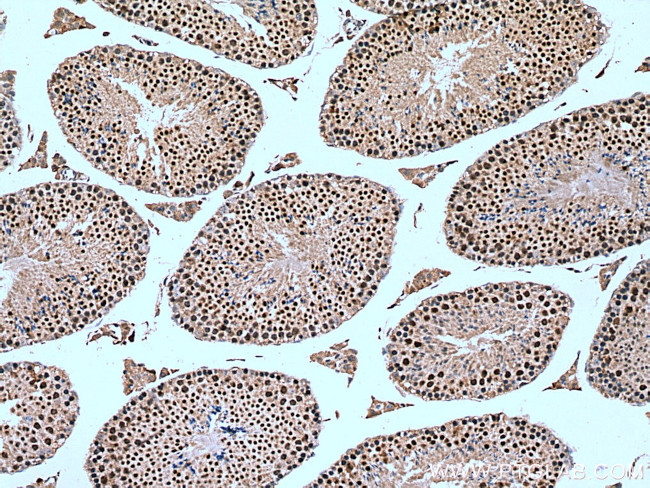
NSMCE2 Antibody in Immunohistochemistry (Paraffin) (IHC (P))

Search
Proteintech
NSMCE2 Polyclonal Antibody
{{$productOrderCtrl.translations['antibody.pdp.commerceCard.promotion.promotions']}}
{{$productOrderCtrl.translations['antibody.pdp.commerceCard.promotion.viewpromo']}}
{{$productOrderCtrl.translations['antibody.pdp.commerceCard.promotion.promocode']}}: {{promo.promoCode}} {{promo.promoTitle}} {{promo.promoDescription}}. {{$productOrderCtrl.translations['antibody.pdp.commerceCard.promotion.learnmore']}}










Please note: We are reviewing Western blot images included in the antibody testing data in our catalog, including those provided by third parties. Unless expressly labeled or annotated as “raw-unedited”, Western blot images included in the antibody testing data in our catalog may have been edited, optimized or otherwise adjusted for presentation.
产品信息
13627-1-AP
种属反应
宿主/亚型
分类
类型
抗原
偶联物
形式
浓度
规格
纯化类型
保存液
内含物
保存条件
运输条件
产品详细信息
Immunogen sequence: MPGRSSSNS GSTGFISFSG VESALSSLKN FQACINSGMD TASSVALDLV ESQTEVSSEY SMDKAMVEFA TLDRQLNHYV KAVQSTINHV KEERPEKIPD LKLLVEKKFL ALQSKNSDAD FQNNEKFVQF KQQLKELKKQ CGLQADREAD GTEGVDEDII VTQSQTNFTC PITKEEMKKP VKNKVCGHTY EEDAIVRMIE SRQKRKKKAY CPQIGCSHTD IRKSDLIQDE ALRRAIENHN KKRHRHSE (1-247 aa encoded by BC032797)
靶标信息
This gene encodes the large subunit of DNA damage-binding protein which is a heterodimer composed of a large and a small subunit. This protein functions in nucleotide-excision repair. Its defective activity causes the repair defect in the patients with xeroderma pigmentosum complementation group E (XPE). However, it remains for mutation analysis to demonstrate whether the defect in XPE patients is in this gene or the gene encoding the small subunit. In addition, Best vitelliform mascular dystrophy is mapped to the same region as this gene on 11q, but no sequence alternations of this gene are demonstrated in Best disease patients.
仅用于科研。不用于诊断过程。未经明确授权不得转售。
生物信息学
蛋白别名: E3 SUMO-protein ligase NSE2; E3 SUMO-protein transferase NSE2; FLJ32440; MMS21 homolog; Non-SMC element 2 homolog; Non-structural maintenance of chromosomes element 2 homolog
基因别名: 1110014D18Rik; AI661537; Mms21; Nsmce2; RGD1305156
UniProt ID: (Mouse) Q91VT1, (Rat) Q4V8A0
Entrez Gene ID: (Mouse) 68501, (Rat) 299957